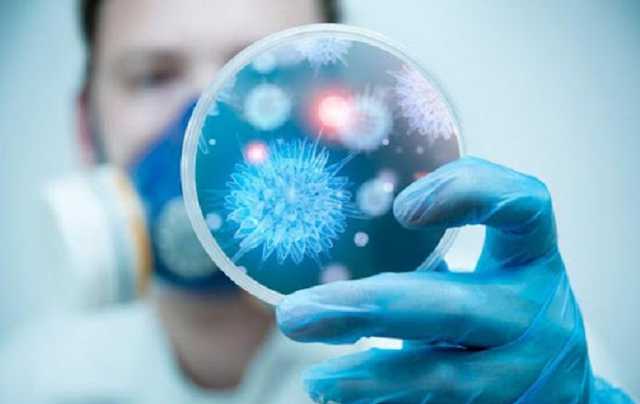
В Ровенской области нашли полиомиелит у семерых детей из семьи антипрививочников

В Ровенской области нашли полиомиелит у семерых детей из семьи антипрививочников
В Ровенской области нашли полиомиелит у семерых детей из семьи антипрививочников
В Ровенской области в семье девочки с тяжелыми симптомами полиомиелита опасный вирус обнаружили еще у шестерых детей. Всего в семье десять братьев и сестер, и всем им не делали никаких плановых прививок, так как родители антипрививочники.
Об этом говорится в сюжете ТСН.
Заболевшая девочка, которой год и четыре месяца, еще недавно выглядела здоровой, пока внезапно перестала вставать на ноги. Ее диагноз подтвердили в лаборатории Хельсинки.
Лечение и реабилитация парализованного ребенка будут длительными, доктора хотят поставить ребенка на ноги, но результат их усилий спрогнозировать нельзя, ведь поражения при этом нервном заболевании необратимы.
У старших детей полиовирус того же штамма, что у девочки. Теперь специалистам предстоит выяснить, откуда он пришел в семью.
Зараженные дети пока чувствуют себя хорошо, симптомов недуга у них нет. Врачи за ними наблюдают, причем вести мониторинг состояния предстоит несколько месяцев. Также медики следят за учениками школы, где учатся зараженные дети.
Несмотря на плачевное состояние младшего ребенка, родители продолжают выступать против прививок. Медики пытаются их уговорить провакцинировать детей.
Теги: ВирусРовенская областьполиомиелитБолезниДети

Коментарі:
comments powered by DisqusЗагрузка...
Наші опитування
Показати результати опитування
Показати всі опитування на сайті











